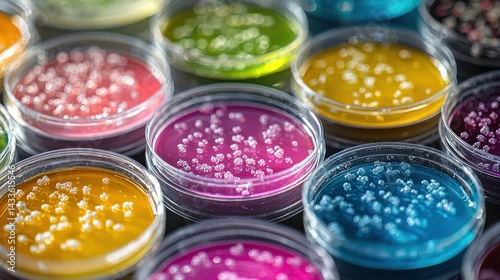

Download sample
File Details
Published: 2025-04-25 14:57:32.995816 Category: Hobbies and Leisure Type: Photo Model release: NoShare
Colorful petri dishes with bacterial colonies in a science lab setting ready for observation.
Contributor: melvilsky
ID : 1433615546
